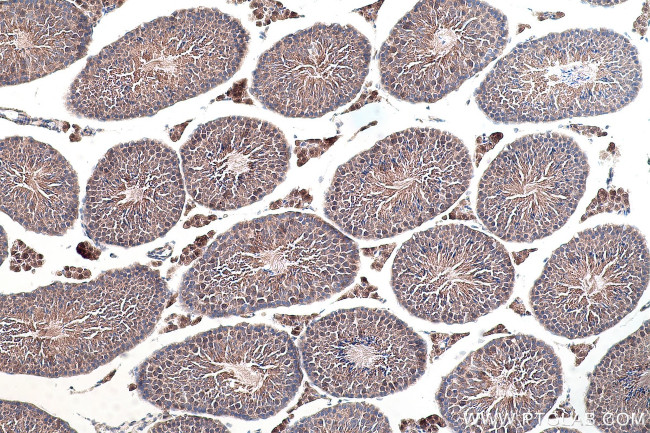
TRUB1 Antibody in Immunohistochemistry (Paraffin) (IHC (P))
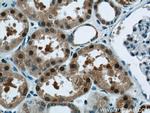
TRUB1 Antibody in Immunohistochemistry (Paraffin) (IHC (P))

Search
Proteintech
TRUB1 Polyclonal Antibody
{{$productOrderCtrl.translations['antibody.pdp.commerceCard.promotion.promotions']}}
{{$productOrderCtrl.translations['antibody.pdp.commerceCard.promotion.viewpromo']}}
{{$productOrderCtrl.translations['antibody.pdp.commerceCard.promotion.promocode']}}: {{promo.promoCode}} {{promo.promoTitle}} {{promo.promoDescription}}. {{$productOrderCtrl.translations['antibody.pdp.commerceCard.promotion.learnmore']}}
产品信息
12520-1-AP
种属反应
宿主/亚型
分类
类型
抗原
偶联物
形式
浓度
规格
纯化类型
保存液
内含物
保存条件
运输条件
产品详细信息
Immunogen sequence: MAASEAAVV SSPSLKTDTS PVLETAGTVA AMAATPSARA AAAVVAAAAR TGSEARVSKA ALATKLLSLS GVFAVHKPKG PTSAELLNRL KEKLLAEAGM PSPEWTKRKK QTLKIGHGGT LDSAARGVLV VGIGSGTKML TSMLSGSKRY TAIGELGKAT DTLDSTGRVT EEKPYDKITQ EDIEGILQKF TGNIMQVPPL YSALKKDGQR LSTLMKRGEV VEAKPARPVT VYSISLQKFQ PPFFTLDVEC GGGFYIRSLV SDIGKELSSC ANVLELTRTK QGPFTLEEHA LPEDKWTIDD IAQSLEHCSS LFPAELALKK SKPESNEQVL SCEYITLNEP KREDDVIKTC (1-349 aa encoded by BC030601)
靶标信息
Pseudouridine is an abundant component of rRNAs and tRNAs and is enzymatically generated by isomerization of uridine by pseudouridine synthase (Zucchini et al., 2003 ).
仅用于科研。不用于诊断过程。未经明确授权不得转售。
篇参考文献 (0)
生物信息学
蛋白别名: probable tRNA pseudouridine synthase 1; Pseudouridylate synthase TRUB1; psi; Psi55 synthase TRUB1; tRNA pseudouridine 55 synthase TRUB1; TruB pseudouridine (psi) synthase family member 1; TruB pseudouridine (psi) synthase homolog 1; TruB pseudouridine synthase homolog 1; unnamed protein product
基因别名: 2610009I02Rik; 9030425C13Rik; AI448235; BB118943; C76870; PUS4; TRUB1
UniProt ID: (Human) Q8WWH5, (Mouse) Q8C0D0
Entrez Gene ID: (Human) 142940, (Mouse) 72133